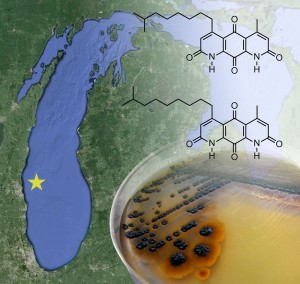
Compounds from Lake Michigan play a key role in the drug discovery efforts of Chicago-based researchers

Time to include Renminbi in SDR basket?
By Yimian Wu Financial experts from Hong Kong said in Chicago Wednesday that November will be a good time to include the renminbi, or RMB,

By Yimian Wu Financial experts from Hong Kong said in Chicago Wednesday that November will be a good time to include the renminbi, or RMB,

By Angela Barnes A Chicago organization is helping to save women’s lives through breast exams, primarily in underserved communities. Here is how one woman’s life

By Taylor Hall On a recent weekend, South Loop resident Christina Rojas and a handful of her closest friends flew from Chicago to Las Vegas

By Empriss Campbell According to the department of labor, Chicago has one of the highest unemployment rates for a large metropolitan area. For those who

By Lukas J. Voss Women have increasingly been part of the sports world. Professional sports, college athletics and the media. All fields in which women

Ryan DeBlock, a former wrestler lost 25 pounds one year and nearly starved himself to death. As a survivor of an eating disorder, he speaks

By Stephanie Choporis A loud knocking woke Brandon Williams one night in late 2014 in his fourth floor apartment on South Shore Drive. “When people

By Bethel Habte The Fueling Station A passing thunderstorm left tiny puddles in the courtyard entrance of Canvas, an art and performance studio in Wicker
by Elise Steinberger While news of a case of extremely drug-resistant tuberculosis in Chicago makes its way across the nation, we ask ourselves, where do

By Yining Zhou Kendo is Japanese sword fighting. It requires not only physical strength but also mental stillness. John Condon is a four-dan kendoka and